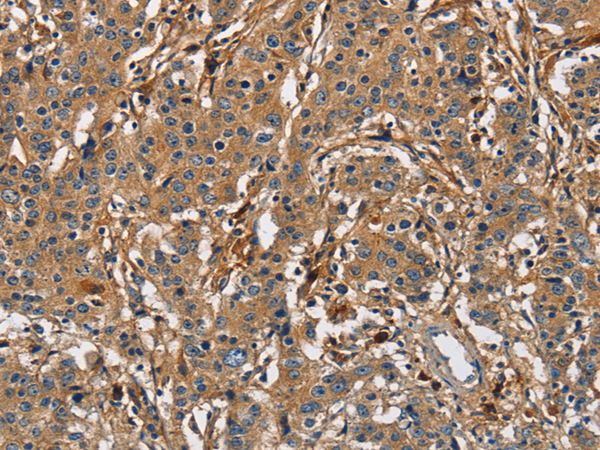

中文名稱:兔抗BLK多克隆抗體
|
Background: |
This gene encodes a nonreceptor tyrosine-kinase of the src family of proto-oncogenes that are typically involved in cell proliferation and differentiation. The protein has a role in B-cell receptor signaling and B-cell development. The protein also stimulates insulin synthesis and secretion in response to glucose and enhances the expression of several pancreatic beta-cell transcription factors. |
|
Applications: |
ELISA, WB, IHC |
|
Name of antibody: |
BLK |
|
Immunogen: |
Fusion protein of human BLK |
|
Full name: |
B lymphoid tyrosine kinase |
|
Synonyms: |
MODY11 |
|
SwissProt: |
P51451 |
|
ELISA Recommended dilution: |
1000-2000 |
|
IHC positive control: |
Human thyroid cancer and Human gastric cancer |
|
IHC Recommend dilution: |
25-100 |
|
WB Predicted band size: |
58 kDa |
|
WB Positive control: |
A172 cells |
|
WB Recommended dilution: |
200-1000 |

購物車
購物車 幫助
幫助
 021-54845833/15800441009
021-54845833/15800441009
